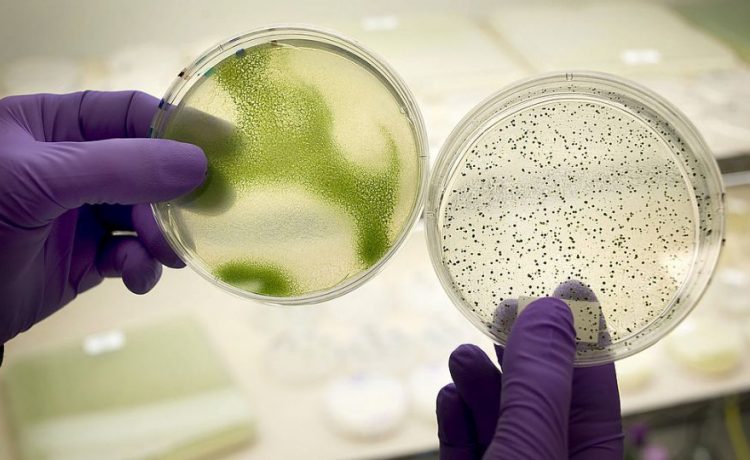
قريبا.. استخدام الطحالب كوقود للسيارات!

المربع نت – بعد الزيادة الكبيرة في تلوث البيئة بسبب الغازات الناتجة من عوادم السيارات، طالبت حكومات الدول من الشركات المصنعة للسيارات البحث عن طرق بديلة للحصول على الطاقة لتسيير السيارات بخلاف الوقود، لذا توجهت معظم الشركات لتصنيع سيارات صديقة للبيئة تمثلت في السيارات الكهربائية والهايبرد.

وعلى الرغم من انخفاض العوادم الضارة بالبيئة التي تنتجها هذه السيارات، إلا أن العلماء وجدوا أن ذلك غير كافي، وإن هذه السيارات تمتلك أثر كربوني ملحوظ على البيئة بسبب ما تحتويه من مكونات ضارة بالبيئة وصعبة بإعادة التدوير.
لذا توجه العلماء للبحث عن وسائل أخرى لتوليد الطاقة تكون نسبة التلوث التي تنتجها منخفضة إلى أقصى درجة، وبالفعل توصل العلماء إلى إمكانية استخدام الطحالب في صنع وقود حيوي للسيارات صديق للبيئة.
حيث لاحظ العلماء هذه النباتات تنتج طاقتها عبر أشعة الشمس، ولكنها عكس النباتات الأخرى تستخدم هذه الأشعة لإنتاج الزيت، ويعتقد العلماء بإمكانية تصفية هذا الزيت بغرض تحويله لوقود طبيعي للسيارات.

ويرى العلماء أن من العوامل التي تساعد على استخدام الطحالب كمصدر رائع للطاقة هو سهولة زراعته، بالإضافة إلى قدرتها على النمو بصورة سريعة خلال أسابيع قليلة، كما يمكن إطعام الطحالب بقايا نباتات أخرى كي تنمو بشكل أسرع.
يذكر أن هذه ليست المرة الأولى لاستخدام النباتات في توليد الطاقة، حيث أن شركات البنزين كثيراً ما كانت تخلط ايثانول الذرة بالبنزين لصنع وقود ذو معدل انبعاثات أقل منذ عدة عقود، إلا أن ما يميز الطحالب هو أن الزيوت الخاصة بها لا تولد أي ملوثات عند حرقها، ما يجعلها الخيار الأنظف بالنسبة للأثر البيئي.

لكن من المعتقد مرور عدة سنوات قبل إمكانية الاستخدام الفعلى للطحالب في توليد الطاقة، حيث لا يزال العلماء يجرون الأبحاث حول أفضل طريقة لاستخراج الطاقة من زيت الطحالب بصورة تجارية، وذلك لوجود أكثر من 100,000 نوع من الطحالب على كوكبنا، ويحاول العلماء حالياً إيجاد الفصيلة الأكثر كفاءة من هذه النباتات لاستخدامها كوقود حيوي.
اشترك بالقائمة البريدية
احصل على أخبار وأسعار السيارات أول بأول




















